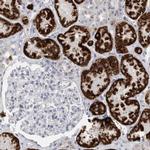
AGMAT Antibody in Immunohistochemistry (IHC)

Search
Invitrogen
AGMAT Polyclonal Antibody
{{$productOrderCtrl.translations['antibody.pdp.commerceCard.promotion.promotions']}}
{{$productOrderCtrl.translations['antibody.pdp.commerceCard.promotion.viewpromo']}}
{{$productOrderCtrl.translations['antibody.pdp.commerceCard.promotion.promocode']}}: {{promo.promoCode}} {{promo.promoTitle}} {{promo.promoDescription}}. {{$productOrderCtrl.translations['antibody.pdp.commerceCard.promotion.learnmore']}}
产品信息
PA5-55311
种属反应
宿主/亚型
分类
类型
抗原
偶联物
形式
浓度
规格
纯化类型
保存液
内含物
保存条件
运输条件
RRID
产品详细信息
Immunogen sequence: MLGTVNPSTG ALPFQSLMVA DLGDVNVNLY NLQDSCRRIQ EAYEKIVAAG CIPLTLGGDH TITYPILQAM AKKHGPVGLL HVDAHTDTTD KALGEKLYHG
Highest antigen sequence identity to the following orthologs: Mouse - 79%, Rat - 80%.
靶标信息
AGMAT (Agmatinase) hydrolyzes agmatine to putrescine and urea. It is highly expressed in liver and kidney and is also found in skeletal muscle, fetal liver, brain, testis, skin and the gastrointestinal tract.
仅用于科研。不用于诊断过程。未经明确授权不得转售。
生物信息学
蛋白别名: agmatinase; agmatinase, mitochondrial; agmatine ureohydrolase; agmatine ureohydrolase (agmatinase); Arginase, mitochondrial; AUH; Guanidino acid hydrolase, mitochondrial; Guanidinobutyrase, mitochondrial; Guanidinopropionase, mitochondrial
基因别名: AGMAT; GDAH
UniProt ID: (Human) Q9BSE5
Entrez Gene ID: (Human) 79814